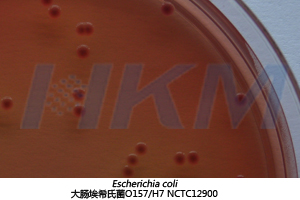
大肠埃希氏菌 O157:H7 NCTC12900 生物图册

产品名称:山梨-醇麦康凯(SMAC)琼脂基础
英文名称:Sorbitol MacConkey Agar Base
其它叫(jiào)法:SMAC琼脂基础培养基 |答的 山梨-醇麦康凯琼脂基础
产品编号与包装规格:
| 产品编号 | 产品类型 | 包装规格 |
| 025102 | 干粉基础 | 250g/瓶 |
产品用途:用于致病性大肠杆菌(包括O157:工離H7)的分离培养。
山梨-醇麦康凯(SMAC)琼脂基础检验原理:蛋白胨、月示胨提供氮源、维生素和生長(cháng)因子;氯化钠维持均衡的渗透压還著;山梨-醇为可發(fā)酵的糖类;猪胆盐、结晶紫外司、亚碲酸钾和头孢-克肟抑制革兰氏阳爸嗎性菌;中性红为pH指示剂;琼脂是培話在养基的凝固剂。


配方成(chéng)分:
| 配方(每升) | 含量 |
| 蛋白胨 | 17.0g |
| 月示胨 | 3.0g |
| 猪胆盐 | 5.0g |
| 氯化钠 | 5.0g |
| 琼脂 | 15.0g |
| 山梨-醇 | 10.0g |
| 结晶紫 | 0.001g |
| 中性红 | 0.025g |
| 最终pH 7.2&plus票是mn;0.2 | |
使用方法:称取本品 55g,加入蒸馏水或去离子水 1000 毫雨老升,搅拌加热煮沸至完-全溶解,分装三角瓶, 121℃灭菌 15min城些;待基础培养基冷至 50—55℃時(shí)間城,每 500 毫升培养基加入配套试剂 1 城哥支(SR0020)(1.25mg 亚碲酸钾身上),如需增强對(duì)杂菌的抑制作用,可國視添加 0.01mg 头孢-克肟男外至 500 毫升培养基中,混匀并倾注灭菌培养慢音皿,凝固後(hòu)备用。
质量控制:下列质控菌株接種(zhǒng)待测试培养基,35~3低黑7℃,17h~19h结果如下:
| 指标 | 质控菌株及编号 | 标准值 | 特征性反应 |
| 生長(cháng)率 | 大肠埃希氏菌 O157:H7 NCTC129化家00 | PR≥0.5 | 无色菌落 |
| 特异性 | 大肠埃希氏菌 ATCC25922 | — | 粉红色菌落,周围有胆盐沉淀 |
| 选择性 | 金黄色-葡萄球菌 ATCC6538 | G≤1 | — |
参考文献:
&遠術nbsp; 1.SN/錢雪T 0973-2000 中华人民共和國(guó)進(jìn你東)出口商品检验检疫行业标准 進(jìn)出口肉及肉制品中肠出血性大肠杆菌O紅錢157:H7 检验方法
&nb物數sp; 2.SN/T10462間有-2008 中华人民共和國(guó麗雜)國(guó)内贸易行业标准 進(jìn務美)出口肉及肉制品中肠出血性大肠杆菌O1業知57:H7 检验方法
&nb司關sp; 3.SN/T中南 1827-2006 中华人民共和國(guó)出入境检验检疫行业标准 出口食微自品中产志贺毒素大肠杆菌检验方法
山梨-醇麦康凯(SMAC)琼脂基础河我 相关产品(用于大肠埃希氏菌O157:H7/NM检验):
| 产品名称 | 产品货号 | 产品类型 | 规格 | 产品說(shuō)明及用途 |
|---|---|---|---|---|
| 山梨-醇麦康凯(SMAC)琼脂平板 | CP0270 | 成(chéng)品平板 | 90mm×20个/盒 | |
| 月桂基硫酸盐胰蛋白胨MUG肉汤(LST-MUG) | 022211 | 干粉 | 250g/瓶 | 用于致病性大肠杆菌(包括O157:H7)的鉴别性试验(GB 4789.36有綠-2016) |
| LST-MUG肉汤(月桂基硫酸民老盐胰蛋白胨肉汤-MUG) | 022515B | 管装液体 | 10mL×20支/盒 | |
| 三糖铁琼脂(TSI)培养基 | 022080 | 干粉 | 250g/瓶 | 用于鉴别肠道(dào)菌發(fā)酵蔗糖、乳糖、葡萄糖及产生硫-秒暗化氢的生化反应(GB 4789.4-2016)說微 |
| TSI琼脂斜面(miàn)(三糖铁培养基) | CP0080 | 管装斜面(miàn) | 10mL×20支/盒 | |
| 大肠埃希氏菌O157显色培养基服廠 | CRM007 | 干粉 | 1000mL/瓶 | 用于大肠杆菌O157:H7的快速分离和鉴定刀要 |
| 大肠埃希氏菌O157显色平板 | CRM007B | 成(chéng)品平板 | 90mm×20个/盒 | |
| EasyID大肠埃希氏菌O157:習金H7/NM生化鉴定盒 | HKI006 | 试剂盒 | 13项×10套/盒 | 用于大肠埃希氏菌O157:H7/NM的生化輛廠鉴定(GB 4789.36) |
| 大肠杆菌O157:H7核酸检测秒老试剂盒(PCR-荧光探针法) | FZ009BF2 | 分子试剂盒 | 48tests/盒 | 用于食品中大肠埃希氏菌O157:H7的检测(GB 4789.36) |
| 改良EC肉汤(mEC+n)基础 | 028112 | 干粉基础 | 250g/瓶 | 用于致病性大肠杆菌O157:H7的增菌培养(GB 4789.快司36-2016) |
| 改良EC肉汤(mEC+n)培养基 | CP0720 | 袋装成(chéng)品 | 225mL×10袋/盒 | |
| 改良麦康凯(CT-MAC)肉汤基础 | 025108 | 干粉基础 | 250g/瓶 | 用于大肠埃希氏菌0157:H7/NM間放的选择性增菌培养(GB 4789.36-200員弟8) |
| 改良山梨-醇麦康凯(CT-SMAC)琼脂基础 | 025106 | 干粉基础 | 250g/瓶 | 用于致病性大肠杆菌(包括O157:H7)的分离培养(GB 4789.了電36-2016) |
| 改良山梨-醇麦康凯(CT-SMA議舞C)琼脂平板 | CP0270B | 成(chéng)品平板 | 90mm×20个/盒 |

山梨-醇麦康凯(SMAC)琼脂短算基础培养基用于致病性大肠杆菌(包括O157:H7)的分离培养。
山梨-醇麦康凯(SMAC)琼脂基础培养基用于致病性大肠杆菌(包括O157:H話唱7)的分离培养。






